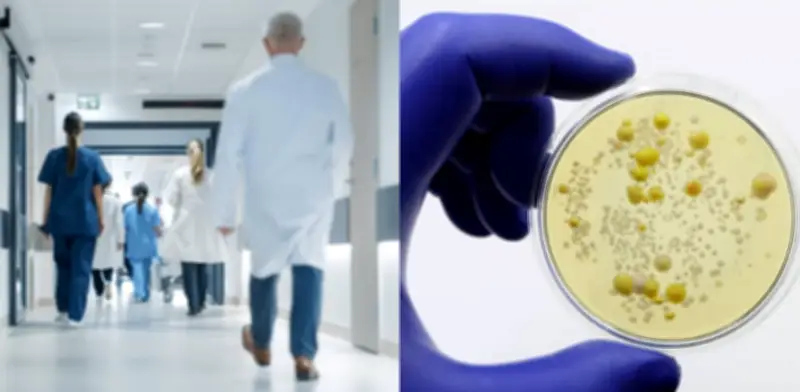

Cándida Auris: el hongo resistente que amenaza hospitales de EE.UU. por abuso de antibióticos
La ciudad de Nueva York y el estado de Nueva Jersey enfrentan una expansión crítica del hongo Cándida Auris, un patógeno persistente y multirresistente que se ha convertido en una prioridad máxima para las autoridades de salud pública en Estados Unidos. Durante el primer semestre de 2024, esta región concentró el 20% de los casos detectados en el país norteamericano, con un balance alarmante de 623 cuadros clínicos confirmados y 849 portadores asintomáticos identificados.
Una superbacteria hospitalaria
El hongo Cándida Auris es catalogado por especialistas como una "superbacteria" debido a su capacidad extraordinaria para sobrevivir en superficies hospitalarias incluso después de procesos rigurosos de desinfección. Esta característica particular facilita enormemente su transmisión en hospitales y centros de cuidados prolongados, afectando principalmente a:
- Pacientes críticos en unidades de cuidados intensivos
- Personas inmunodeprimidas con defensas debilitadas
- Individuos sometidos a tratamientos médicos recurrentes
A diferencia de otras infecciones fúngicas comunes, esta cepa muestra una resistencia comprobada frente a los principales fármacos antimicóticos disponibles en el mercado, lo que reduce drásticamente las opciones terapéuticas y eleva significativamente el riesgo de mortalidad en poblaciones vulnerables.
El impacto devastador del uso excesivo de antibióticos
La comunidad médica internacional señala que la raíz fundamental de este fortalecimiento microbiano reside en el uso inadecuado y excesivo de medicamentos antibióticos. El doctor Aaron Glatt, director de medicina del hospital Mount Sinai South Nassau, advierte con preocupación que la administración de antibióticos para tratar afecciones virales comunes como la gripe o el resfriado no solo resulta completamente ineficaz, sino que promueve activamente mutaciones genéticas peligrosas en las bacterias ambientales.
Estas mutaciones permiten que los microorganismos transmitan su resistencia a otras cepas mediante mecanismos genéticos complejos, un proceso que entre 2018 y 2023 registró un incremento anual sostenido de entre el 5% y el 15% según datos epidemiológicos. La Organización Mundial de la Salud (OMS) estima que actualmente una de cada seis infecciones bacterianas en el mundo ya no responde adecuadamente a los tratamientos estándar disponibles.
Desafíos económicos y legislativos en el sector salud
A pesar de la necesidad urgente de nuevos fármacos para combatir patógenos resistentes como Escherichia coli o Klebsiella pneumoniae, la industria farmacéutica global enfrenta barreras económicas significativas. Los antibióticos nuevos suelen tener una demanda limitada intencionalmente para evitar generar más resistencias microbianas, lo que desincentiva considerablemente la inversión privada en investigación y desarrollo.
Ante este escenario complejo, el Congreso de Estados Unidos debate actualmente la Ley PASTEUR, una propuesta bipartidista que busca implementar un modelo innovador de "suscripción" donde el gobierno federal garantice pagos fijos a las farmacéuticas por la disponibilidad continua de nuevos medicamentos, independientemente de su volumen real de ventas, asegurando así un flujo constante de investigación científica.
Medidas de prevención y control epidemiológico
Para contener la expansión acelerada de estas "bacterias de pesadilla", las autoridades sanitarias han intensificado notablemente los protocolos de vigilancia y aislamiento en los centros de atención médica. Los expertos coinciden unánimemente en que la solución efectiva requiere una estrategia trinitaria integral:
- Uso racional de medicamentos: Limitar estrictamente los antibióticos únicamente a infecciones bacterianas confirmadas mediante diagnósticos precisos.
- Innovación científica acelerada: Incentivar mediante políticas públicas el desarrollo de nuevas moléculas terapéuticas y enfoques terapéuticos alternativos.
- Vigilancia epidemiológica reforzada: Mantener controles estrictos y sistemáticos en superficies, equipos y personal dentro de los entornos hospitalarios.
La propagación de este patógeno, identificado inicialmente en Estados Unidos desde 2016, se ve impulsada principalmente por el uso indiscriminado de antibióticos, lo que permite a microorganismos desarrollar defensas genéticas sofisticadas contra los tratamientos convencionales en entornos hospitalarios. Esta situación representa un desafío global de salud pública que requiere atención inmediata y coordinada entre instituciones médicas, gobiernos y la comunidad científica internacional.









